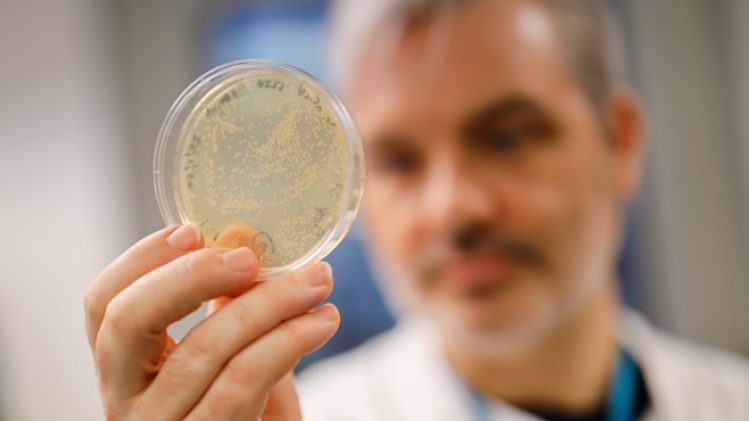
coronavirus

Le nouveau coronavirus s'appellera officiellement 'Covid-19', a annoncé mardi le directeur général de l'Organisation mondiale de la santé (OMS) à Genève. Cette dénomination remplace celle de 2019-nCoV, décidée à titre provisoire après l'apparition de la maladie. La nouvelle dénomination a été choisie de manière à être "facile à prononcer", tout en restant sans référence "stigmatisante" à un pays ou une population particulière, a souligné Tedros Adhanom Ghebreyesus.
Une "très grave menace" pour le monde
Le nouveau coronavirus constitue une "très grave menace" pour le monde, a assuré mardi le directeur général de l'Organisation mondiale de la santé (OMS). "Avec 99% des cas en Chine cela reste une grande urgence pour ce pays, mais cela constitue aussi une très grave menace pour le reste du monde", a déclaré Tedros Adhanom Ghebreyesus à l'ouverture à Genève d'une conférence de l'OMS sur la maladie. Quelque 400 scientifiques doivent passer en revue durant deux jours les moyens de combattre l'épidémie, en se penchant sur sa transmission et sur les traitements possibles. "Ce qui importe le plus, c'est d'arrêter l'épidémie et de sauver des vies. Avec votre soutien, c'est ce que nous pouvons faire ensemble", a déclaré le chef de l'OMS aux participants. Il a notamment appelé tous les pays à faire preuve de "solidarité" en partageant les données dont ils disposent. "C'est particulièrement vrai pour ce qui concerne les échantillons et le séquençage (du virus). Pour vaincre cette épidémie, nous avons besoin d'un partage équitable", a-t-dit.
Il a espéré que cette réunion débouche sur une "feuille de route" en matière de recherche, sur laquelle "les chercheurs et les donateurs puissent s'aligner". Plus de 42.600 personnes ont été contaminées par ce virus en Chine continentale, et au moins 1.016 d'entre elles sont mortes. En dehors de la Chine continentale, le virus a tué deux personnes, une aux Philippines et une autre à Hong Kong, et plus de 400 cas de contamination ont été confirmés dans une trentaine de pays et territoires.